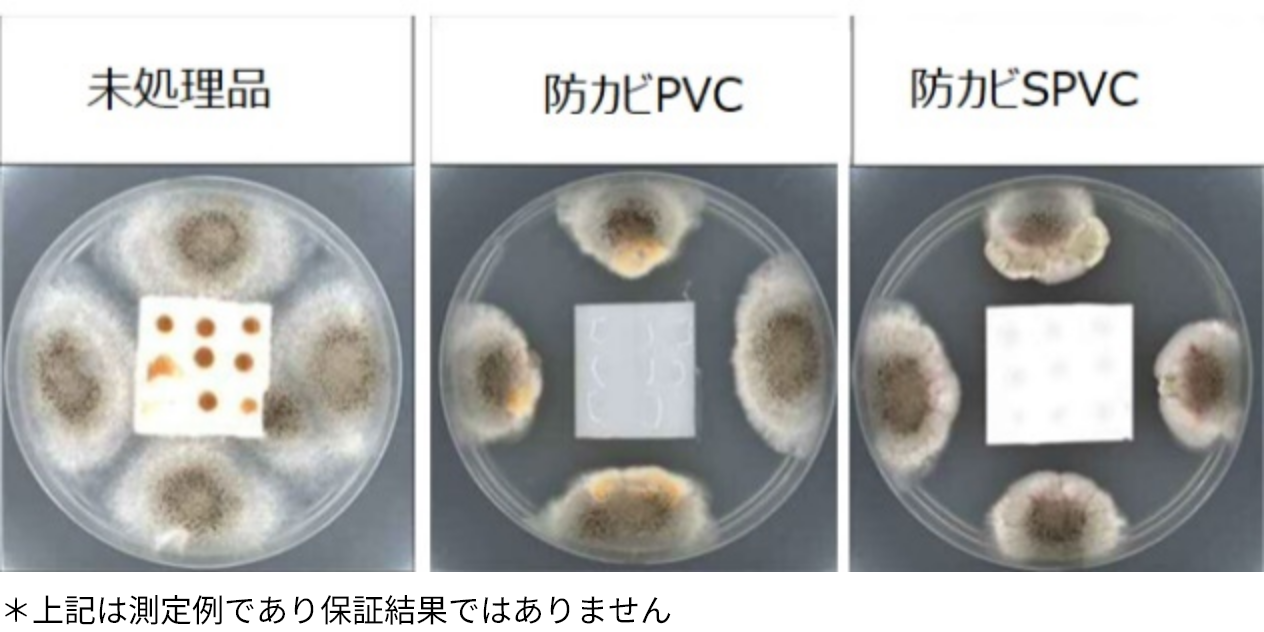

新たな樹脂で、
新たな価値を―

機能性樹脂
化学のチカラでお客様の想いをカタチにしたいという、我々フクビ化学の願い。樹脂に機能性を与え、新たな価値を創造します。共に挑戦しつづけ、サステナブルな未来を切り拓いていきたい。機能性樹脂ならフクビ化学にお任せください。
Plaslipとは
Plaslipとは、樹脂との親和性に優れた摺動成分を練りこむと共に、フクビ化学独自の配合技術を組み合わせることで相乗的に摺動性を高めた樹脂素材です。
Plaslipを活用する事で滑り性や、音鳴り防止、防汚性の向上など様々なメリットを得る事ができます。
ラインナップ
- 軟質Plaslip
- 硬質Plaslip
- 硬質Plaslip(高持続タイプ)
さまざまな樹脂に対応可能ですのでお気軽にお問い合わせください。
COEFFICIENT
動摩擦係数(スリップテスター)
一般樹脂に比べて動摩擦係数が小さく製品の動きをスムーズにすることが可能です。

スティックスリップ/音鳴り防止効果
一般樹脂に比べ、スティックスリップ現象が少なく音鳴り防止効果が期待できます。

SUSや木材製品などでスティックスリップ現象よる音鳴りにお困りの際もPlaslipをご検討ください。

硬質Plaslip(高持続タイプ)は、通常のPlaslipよりも耐久性に優れ、激しい摩耗が予想される環境で使用しても性能低下が少ないです。
(サンドペーパーで表面を激しくあらしても高持続タイプであればスティックスリップ現象が発生しにくいです)

防汚性
耐候性が高く、屋外での使用も検討可能です。
0.12%カーボン分散水:1mlの汚染物質で汚染後に流水洗浄×10サイクル後の外観

0.12%カーボン分散オレイン酸:1mlの汚染物質で汚染後に流水洗浄×10サイクル後の外観

*上記は測定例であり保証値ではありません
*上記は自社法による測定結果です
耐薬品性
薬品や洗剤への耐久性にも優れます。

防カビ性
別途防カビ材を配合する事も可能です。
(JIS Z 2911:201 カビ抵抗性試験方法)
活用事例
-
引き戸レール 
-
工場
ローラーコンベア
-
樹脂サッシ 
-
トラック
後ろ扉パッキン
-
浴室目地材 
-
ショーケース 
ハイヒートとは
ハイヒートとは、一般PVC、一般ABSよりも耐熱性・難燃性・寸法安定性に優れる、フクビ化学独自の樹脂素材です。
さらに低発煙性にも優れており、発煙の心配があるところにもご使用いただけます。
フクビ化学が培ってきた成形技術を駆使する事で、様々な異形形状への対応を可能としました。
PROPERTIES
基本物性

寸法安定性
加熱収縮率が小さく、一般樹脂に比べ高温下での寸法安定性に優れます。
ハイヒートは加熱収縮率が小さい (高温にさらしても収縮が少ない)



*上記は測定例であり保証値ではありません
*開発品の為、今後予告なく物性値を変更する可能性があります
※70℃アニール後に測定

※270㎜の試験体を対象に、常温施工後、夏季を経て冬季(0℃)になった場合の寸法変化をシミュレーション

活用事例
-
サッシ 下枠 
-
スプリンクラー部材 
-
ブラインド 
-
シャッター内側 
-
太陽光発電
配線カバー
納品までの流れ
- お問い合わせ
-
仕様の打合せ
弊社担当者(場合によっては技術者) よりご要望の詳細を伺いまして、
既存ラインナップにて対応可能かどうかの判断を致します。 - お見積り(金型費用含)
-
金型ご発注-試作品のご提供
新規設計内容がFixとなれば、
金型製作となります。
金型製作から試作品のご提供までに、約2ヶ月かかります。 -
試作品のご承認
試作品をお客様にてご評価いただき、
良好となれば
納入仕様書を締結の上、初回生産となります。 - ご注文
- 出荷・納品
会社概要

フクビ化学工業株式会社
化学のチカラで、
想いをカタチに。
私たちは、創業以来、化学に立脚した樹脂成形技術によって、
様々な分野の日常を、支え続けてまいりました。
フクビならではの化学のチカラで、新たな価値を生み出すこと。
お客様の想いをカタチにするために、挑戦し続けること。
化学のチカラで、想いをカタチに。
私たちは、プラスチックの開発型メーカー、フクビ化学工業です。

-
フクビ化学工業株式会社
-
昭和28年5月25日
-
21億9390万円
-
代表取締役 会長CEO 八木 誠一郎代表取締役 社長執行役員COO 森 克則
-
〒918-8585 福井県福井市三十八社町33-66
-
建築資材の製造・販売
住宅用内装材・外装装飾部材、集合住宅用床システムなど
樹脂製産業資材の製造・販売
精密化工製品製造・販売
反射防止などの機能性精密樹脂製品など

